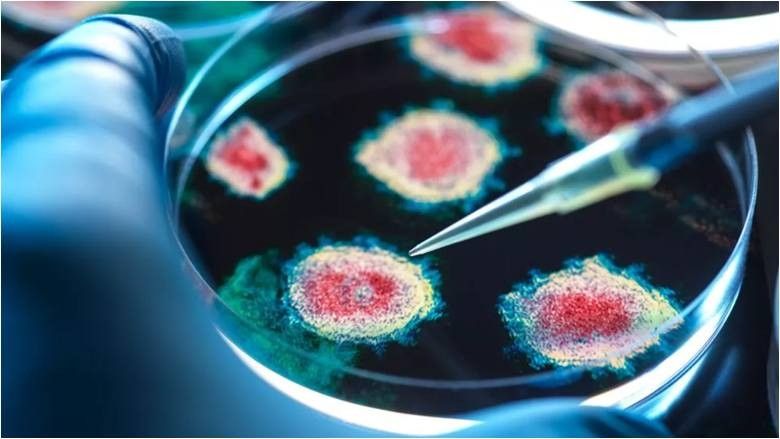

Çfarë është virusi i Sudanit dhe kush duhet të jetë i shqetësuar?
Qeveria e Ugandës dhe Organizata Botërore e Shëndetësisë konfirmuan kohët e fundit një “shpërthim” të sëmundjes së virusit të Sudanit.
Rasti i parë (i njohur) i këtij shpërthimi mendohet të jetë një infermier 32-vjeçar nga një spital në Kampala, kryeqyteti i Ugandës.
Ndërkohë, OBSH raportoi dy grupime kryesore, të lidhura me familjen e pacientit dhe një grup spitalor, shkruajnë mediat e huaja, përcjell Telegrafi.
Në kohën e shkrimit, rasti është vdekja e vetme e regjistruar. Rasti i dytë ishte gruaja e pacientit dhe që nga 11 shkurti, ishin nëntë raste të konfirmuara.
Sipas mediave të huaja, ky shpërthim i ri është i nënti që është regjistruar që nga viti 1976 kur virusi u identifikua për herë të parë dhe – siç ishte praktika në atë kohë – u emërua sipas vendndodhjes ku ndodhi ky shpërthim i parë, Sudani jugor.
Një shpërthim i virusit të Sudanit në vitin 2022 gjithashtu në Ugandë rezultoi në 164 raste dhe 77 vdekje (një shkallë vdekshmërie prej 47%).
Siç theksohet më tej, nuk ka trajtime apo vaksina kundër virusit të Sudanit.
Por sëmundja e virusit të Sudanit është në thelb një sëmundje shumë e ngjashme me Ebolën.
Bëhet fjalë për virusin Ebola që ka shkaktuar disa shpërthime. Shpërthimi i Afrikës Perëndimore 2014-16 ishte më i madhi me 28,600 raste dhe 11,325 vdekje.
Viruset e Sudanit dhe Ebola vijnë nga familja e viruseve të ortoebolës, por ato kanë proteina dhe komponentë gjenetikë të ndryshëm, kështu që përgjigja imune ndaj secilit virus është e ndryshme.
Si e tillë, mendohet se vaksinat e Ebolës nuk do të jenë efektive kundër virusit të Sudanit.
Kështu, për shpërthimin aktual të virusit të Sudanit, ka përpjekje për të vendosur kandidatë për vaksina dhe gjithashtu ilaçe të antitrupave monoklonale.
Këto ilaçe krijojnë antitrupa që synojnë të ndalojnë riprodhimin e virusit.
Ndërkohë, theksojnë mediat e huaja, përcjell Telegrafi, ngjashmëritë në strukturë midis këtyre dy llojeve të ortoebolavirusit nënkuptojnë se simptomat tek pacientët janë të ngjashme.
Sëmundja për të dy viruset zakonisht mund të fillojë me ethe, dhimbje dhe lodhje me progresion të mundshëm në diarre, të vjella dhe gjakderdhje të pashpjegueshme.
Andaj, testet laboratorike janë të nevojshme për të bërë dallimin midis sëmundjeve, megjithëse nevoja urgjente për izolim mbetet.
Gjithashtu, trajtimi i hershëm mbështetës është treguar se zvogëlon shkallën e vdekshmërisë së sëmundjes së virusit Sudan dhe Ebola, duke i dhënë pacientit kohë që trupi i tyre të shërohet.
Kjo zakonisht përfshin zëvendësimin e lëngjeve dhe trajtimin e dhimbjes, etheve dhe infeksioneve të tjera të mundshme.
Siç paralajmërohet në fund, ndryshimet klimatike do të kenë një efekt në shpërndarjen gjeografike të infeksioneve të reja dhe të reja, të tilla si sëmundja e virusit Ebola dhe Sudani dhe virusi Krime-Kongo.
Andaj, bashkëpunimi ndërkombëtar për adresimin e kërcënimeve globale shëndetësore është jetik. /Telegrafi/